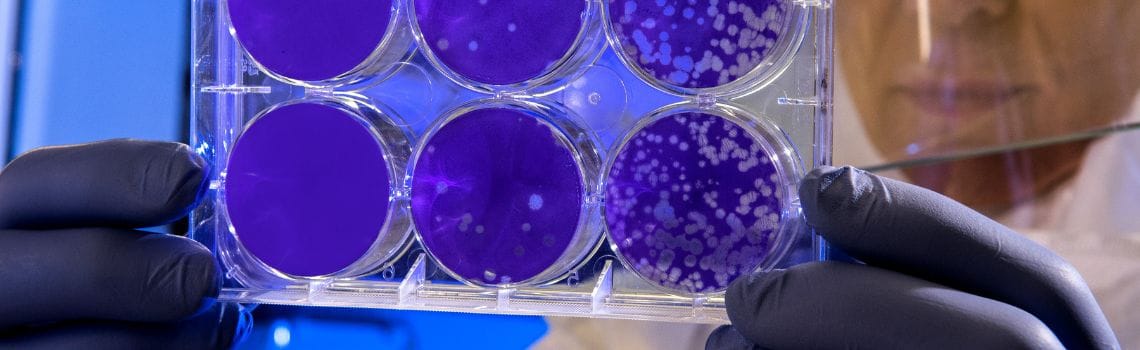
Biotechnologie Profil Header Bild

Allgemeines
Biotechnologie ist ein vielseitiger Studiengang, der sich mit der Anwendung der Biologie in technischen und industriellen Bereichen befasst. Ziel ist es, den Einsatz von Lebewesen in der Industrie zu optimieren und neue Möglichkeiten dafür zu entwickeln. Die Studierenden werden in den Bereichen Biotechnik, Bioinformatik, Gentechnik, Mikrobiologie und Molekularbiologie unterrichtet. Sie lernen auch, wie man die verschiedenen Techniken und Verfahren anwendet, um neue Produkte und Anwendungen zu entwickeln. Darüber hinaus erhalten sie eine fundierte Ausbildung in den Grundlagen der Biologie und der Chemie.
Nach Abschluss des Studiums kannst du in eine Vielzahl an Berufen in der Industrie und in der Forschung einsteigen.
🎉 Prima!
Du erhältst die von dir ausgewählten Informationen schnellstmöglich durch die Hochschulen via Email bzw. Postversand zugestellt.
Alle Biotechnologie Studiengänge
Empfohlene Studiengänge
Empfohlene Hochschulen
Erfahrungen zum Biotechnologie Studium
Hochschulranking: Beliebte Hochschulen für Biotechnologie
Welcher Master nach dem Bachelor Biotechnologie
Nach dem Biotechnologie Bachelor stehen dir verschiedene Master-Studiengänge offen. Du kannst dich zum Beispiel für einen Master in Biotechnologie entscheiden, um deine Kenntnisse in diesem Bereich weiter zu vertiefen. In diesem Studiengang lernst du fortgeschrittene Techniken und Methoden der Biotechnologie kennen und kannst dich auf spezifische Teilbereiche wie z.B. Medizinische Biotechnologie oder Pflanzenbiotechnologie spezialisieren. Eine weitere Möglichkeit ist ein Master-Studium in Molekularer Biotechnologie. Hier liegt der Fokus auf der Erforschung und Anwendung von molekularen Prozessen in der Biotechnologie. Du beschäftigst dich mit Themen wie Genexpression, Proteinproduktion und Gentechnik. Wenn dich eher die pharmazeutische Seite der Biotechnologie interessiert, kannst du dich für einen Master in Pharmazeutischer Biotechnologie entscheiden. In diesem Studiengang lernst du, wie biotechnologische Verfahren in der Arzneimittelentwicklung eingesetzt werden können. Du beschäftigst dich mit der Herstellung von biotechnologischen Arzneimitteln und der Entwicklung neuer Therapien. Ein weiterer möglicher Master-Studiengang ist Bioinformatik. Hier kombinierst du biologisches Wissen mit informatischen Methoden und Werkzeugen, um biologische Daten zu analysieren und zu interpretieren. Du lernst, wie du komplexe biologische Fragestellungen mithilfe von Computermodellen und Algorithmen lösen kannst. Zusätzlich zu diesen spezifischen Master-Studiengängen gibt es auch interdisziplinäre Studiengänge wie Biotechnologie und Management oder Biotechnologie und Umweltwissenschaften. In diesen Studiengängen werden neben den biotechnologischen Inhalten auch betriebswirtschaftliche oder umweltwissenschaftliche Aspekte behandelt. Die genannten Master-Studiengänge sind nur einige Beispiele und es gibt noch viele weitere Möglichkeiten, je nachdem welche Schwerpunkte und Interessen du hast.
Biotechnologie Studium: Welche Berufsaussichten habe ich?
Du wirst mit einem Biotechnologie Studium eine breite Palette an Karrieremöglichkeiten haben. Du könntest in der Forschung und Entwicklung von neuen Medikamenten, Impfstoffen und Therapien arbeiten. Du könntest auch in der Lebensmittel- und Agrarindustrie tätig sein, um neue Technologien zur Verbesserung der Ernteerträge und der Lebensmittelsicherheit zu entwickeln. Darüber hinaus könntest Du in der Umwelttechnologie arbeiten, um Lösungen für Umweltprobleme wie Wasserverschmutzung und Klimawandel zu finden. Es gibt auch Möglichkeiten in der Biotechnologie-Industrie, um Produkte und Dienstleistungen zu verkaufen oder zu vermarkten. Mit einem Biotechnologie Studium hast Du die Möglichkeit, einen positiven Einfluss auf die Welt zu haben und innovative Lösungen für komplexe Probleme zu finden.
